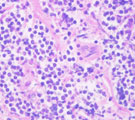

呼吸器 1-i 猫の頚部気管狭窄に対しTチューブを設置した1例
| 雑種猫、メス、11歳8ヶ月。体重2.32kg。呼吸困難を示した猫に胸部X線写真において気管の狭小化がみられ精査治療目的のため、当院紹介診療となった。ゼファー動物病院(八王子)飯野先生からの紹介。 | |||
 |
 |
|
 |
| 初診時頸胸部X線所見。頚部気管狭小化が認められた。 | 気管支鏡所見。喉頭直下の狭窄。全周性粘膜肥厚、凹凸不整あり。 | 粘膜肥厚部の病理組織所見。間質に軽度の線維化を伴ったリンパ球主体の炎症細胞浸潤あり。 | Tチューブ設置後頸胸部X線所見。気管開存し、努力呼吸が消失した。 |
| 経過:受診時、T:37.4℃、P:138/分、R: 28。著しい吸気努力。吸気時に頚部気管中央部に強い高音調喘鳴音あり。頚部触診にてマス病変なし。SpO2<90%。血液ガス分析にてpHa 7.34, Paco2 56 mmHg, Pao2 64 mmHg, [HCO3-] 29.4 mmol/L, A-aDo2 19 mmHgと、重度な肺胞低換気所見を示した。肺機能には異常なく、中枢気道閉塞によると考えられ、気道開存処置で症状改善することが見込まれた。ただちに酸素室管理とした。同日、気管支鏡検査にて喉頭直下に全周性粘膜肥厚と粘膜表面の凹凸不整がみられた。最狭窄部を気管切開後、外径6mmのTチューブを設置した。術後、呼吸困難は消失した。気管支鏡下粘膜生検にて、間質に軽度の線維化を伴ったリンパ球主体の炎症細胞浸潤の病理組織所見が得られた。生検標本洗浄液の培養にて菌は検出されなかった。気道ステント処置に加え、ネブライゼーション(ステロイド、エピネフリン、抗生剤)およびステロイド・CPシロップ内服にて術後管理を行った。術後10日目に、血液ガス分析にてpHa 7.34, Paco2 30 mmHg, Pao2 95 mmHg, [HCO3-] 15.8 mmol/L, A-aDo2 18 mmHgと、肺胞低換気所見は消失し、正常化したので、退院とし自宅管理となった。2ヶ月後に、気管支鏡検査で内部観察後、可能であればTチューブを抜去を試みることになった。 | |||
| コメント: | |||